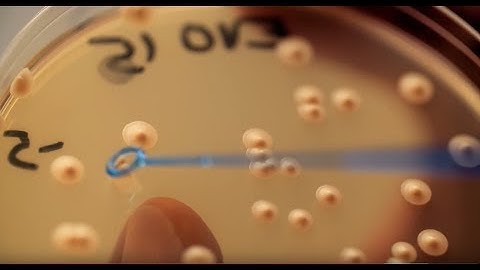
Carlsberg presents: the cultivation of yeast

⬇ DOWNLOAD NOW
Kalau muncul iklan pop-up, tutup lalu klik tombol kembali
Download lagu CellDrop Applications | Counting Yeast secara gratis hanya untuk keperluan promosi. Dukung artis favorit kamu dengan membeli musik original di iTunes atau platform resmi lainnya.
Carlsberg presents: the cultivation of yeast
Carlsberg presents: the cultivation of yeast
 ExtraCell Yeast Production Site - Enzym Group, Ukraine
ExtraCell Yeast Production Site - Enzym Group, Ukraine
 How yeast is made - Lesaffre
How yeast is made - Lesaffre
 The coproducts of yeast for the environment - Lesaffre
The coproducts of yeast for the environment - Lesaffre
![Yeast Machine - Your Analogy (Official Video) [Stoner Rock | Grunge | Alternative Rock]](https://i.ytimg.com/vi/uQGlG3bWOOg/hq720.jpg?sqp=-oaymwEjCOgCEMoBSFryq4qpAxUIARUAAAAAGAElAADIQj0AgKJDeAE=&rs=AOn4CLDOhEUQoNohnspcy5hdRG5-ZIXQ6g) Yeast Machine - Your Analogy (Official Video) [Stoner Rock | Grunge | Alternative Rock]
Yeast Machine - Your Analogy (Official Video) [Stoner Rock | Grunge | Alternative Rock]
 Yeast Fermentation Under the Microscope
Yeast Fermentation Under the Microscope
 Counting Isolated Nuclei on a CellDrop | Tech Team Tips
Counting Isolated Nuclei on a CellDrop | Tech Team Tips
 Yeast Explained | Scutoid Studios
Yeast Explained | Scutoid Studios